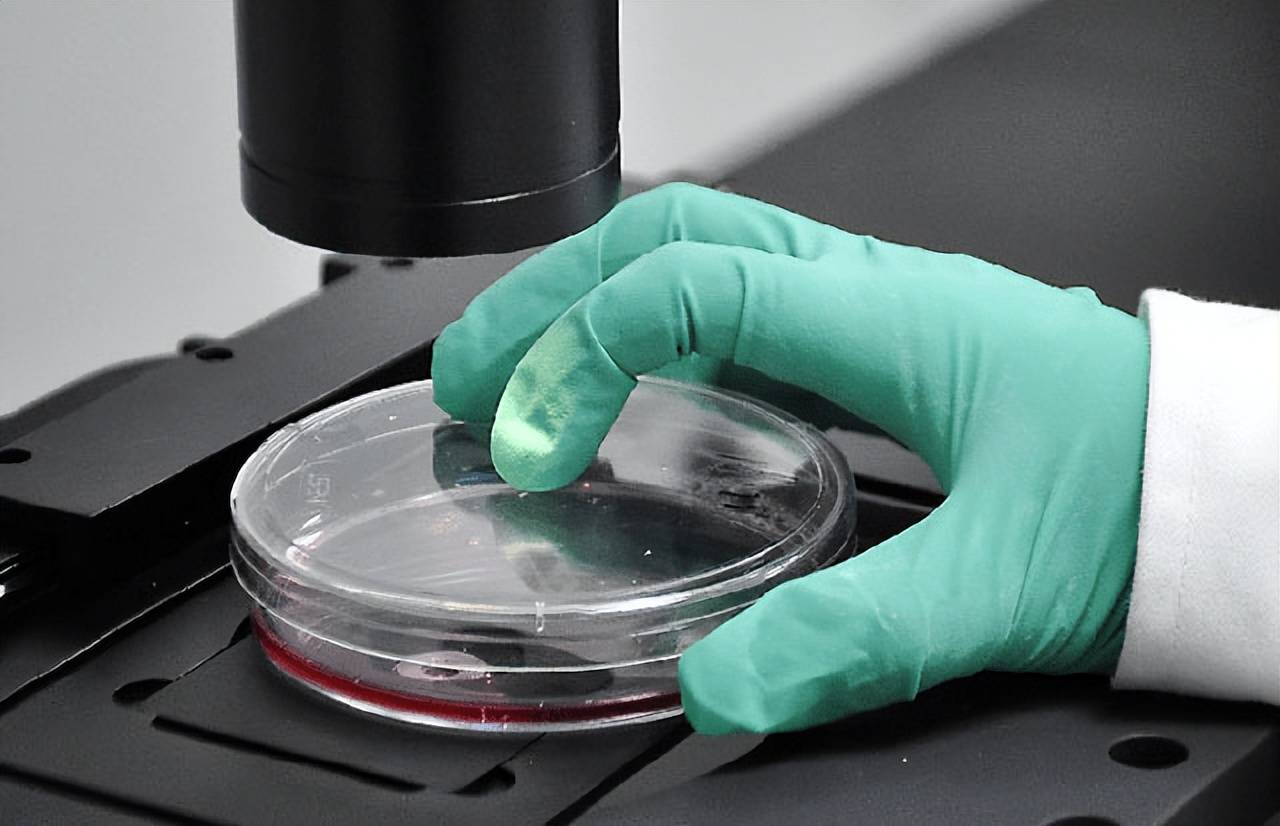

在这个谈癌色变的社会,越来越多的医疗技术为我们带来了无限的曙光,可此时大家也要擦亮眼睛分清事情的本质。

如“只需要120万一针,就能够消灭癌细胞吗?” 这种说法有科学依据吗?
传言中的“一针”,所指的是细胞免疫疗法,它本质上并不是某种“神仙妙药”,更不会消灭所有的癌细胞,它只是一套利用“活细胞当药物”的治疗,把人体自身或者是供体的免疫细胞拿到外面来,如此进行“基因改造、扩增”,最终再输回到患者的体内。

而这种“癌细胞清零”的范围,所针对的也只是某些血液肿瘤,如可能效果较好的白血病、淋巴林等等,而对于其他的实体肿瘤效果很有限。简单来说,这种细胞免疫疗法并不适合所有的癌症患者,也不是所有人都能适用于这种方式。
更需要大家清楚的是,即便是在有效的血液肿瘤治疗上,也并不能保证其疗效就一定是100%的。根据目前临床上的结果来看,部分产品和适应该疗法的患者或许在10年内的生存率超过50%,80%左右的病情可能会得到缓解,特别注意的是,并不是所有患者都是如此。
再加上在国内这种疗法费用非常高,也并没有纳入到医保中,需要大家完全自费,这是许多人都不愿意尝试的,以及还需要有相关的经济条件。
另外,在具体的实体肿瘤上,目前的癌症治疗技术取得到了很大的进步,可仍然有无法被根治的肿瘤。

比如在日常生活中常见以及我国排名比较靠前的肝癌、肺癌、胃癌、胰腺癌等等,当这样的恶性肿瘤进入晚期之后,并且转移之后,从当前的医疗方式上,可能只是控制病情,最大程度延长患者的生存期以及提高其生活质量,无法清除所有的癌细胞。
当然,部分癌症无法被治愈,但可以通过改善不良的生活方式,或者是通过规范的治疗将癌症变成可以控制的“慢性病”,这对于癌症患者也是很大的帮助。

并且,所有癌症都是可以预防的,这还需要大家平时下功夫,做到早预防、早发现、早诊治,注意定期体检以及重视早期症状至关重要。
为此,大家应科学对待自己看到的所有知识,拥有正确的判断力。